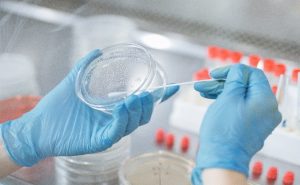
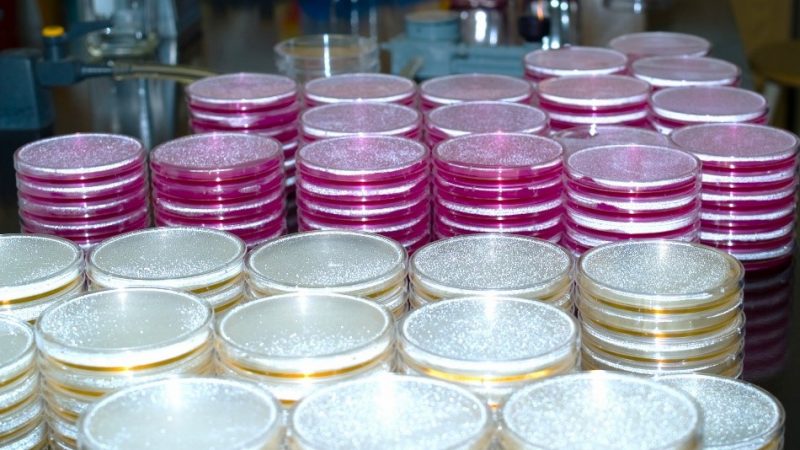
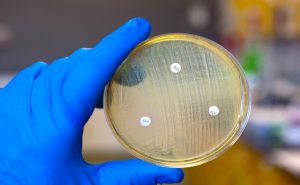

Microbiology Analysis
Microbiology analysis is essential for developing alternative treatments for infectious diseases, besides assuring the product’s quality and encouraging innovation while complying with safety standards. The findings offer extensive information on the antimicrobial properties of the sample or product. TuAH offers four types of antimicrobial testing which is Disk Diffusion Assay (DDA), Minimum Inhibitory Concentration (MIC), Minimum Bactericidal Concentration (MBC), and Antibiotic Susceptibility Test (AST), which complies with the Clinical and Laboratory Standards Institute (CLSI) guidelines. The common bacteria include Staphylococcus aureus (ATCC 6538P), Escherichia coli (ATCC 8739), Pseudomonas aeruginosa (ATCC 15442), and Bacillus subtilis (ATCC 6633).
DISK DIFFUSION ANALYSIS (DDA)
The disk diffusion method is a fundamental test to observe the antimicrobial susceptibility of a sample or product. In this method, we measured the diameter of the inhibition zone and interpreted the results as susceptible or resistant to the bacteria, according to the established guidelines.
MINIMUM INHIBITORY CONCENTRATION (MIC) AND MINIMUM BACTERICIDAL CONCENTRATION (MBC)

MIC testing requires different concentrations of the sample or product. MIC provides data on the lowest concentration of the sample or product to inhibit the growth of bacteria. We performed the testing in a 96-well plate and provided statistical analysis as part of the service. MIC data serves as the basis for MBC testing that will identify the lowest concentration for the sample or product to kill the bacteria. Both testing is vital in the development of new antimicrobial drug because inhibiting bacteria growth doesn’t necessarily mean killing bacteria.
ANTIBIOTIC SUSCEPTIBILITY TEST
AST testing identifies the effectiveness of the antibiotic against specific bacterial infections. It is beneficial for assessing the intended treatments and preventions of our sample or products towards the infection. Our service offers various types of antibiotics, following the customer’s requirements.
Join us, we are ready to offer you our best services.
Contact
Nur Ezzaty Mohd Badrul Isham
03-5544 4526
nurezzaty.tuah@bioextreem.com
 English
English 中文 (中国)
中文 (中国) Bahasa Melayu
Bahasa Melayu